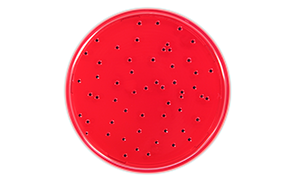
Protocol: <i>Salmonella</i> Detection Procedure (EN ISO 6579-1) Protocol: <i>Salmonella</i> Detection Procedure (EN ISO 6579-1)

Partnerships & Programs: Partner with us to achieve your goals while maximizing your budget.
Microbiological Testing Learning Hub
Introduction
Welcome to the Microbiology Testing Learning Center, a dedicated hub for applied scientists focused on advancing their expertise in microbial testing. This resource is essential for professionals in critical industries such as pharmaceutical quality control, food and beverage manufacturing, and cosmetics. Our platform features a diverse range of materials, including technical articles, innovative methods, and practical techniques. You’ll find valuable brochures and engaging webinars designed to equip you with the skills and knowledge necessary for effective pathogen detection and environmental monitoring, ensuring compliance with industry standards.
In the ever-evolving field of microbial analysis, staying informed is key to ensuring product safety and quality. The Microbiology Testing Learning Center is committed to providing cutting-edge content that addresses the unique challenges faced by scientists in various sectors. Our extensive library covers vital topics such as hygiene monitoring, quality assurance strategies, and the latest advancements in microbial testing methodologies. By utilizing our resources, you can enhance your understanding and application of microbiological practices, ultimately contributing to the success and reliability of your products. Join us today and elevate your microbial testing capabilities!
Webinars
Related Learning Hubs
To continue reading please sign in or create an account.
Don't Have An Account?